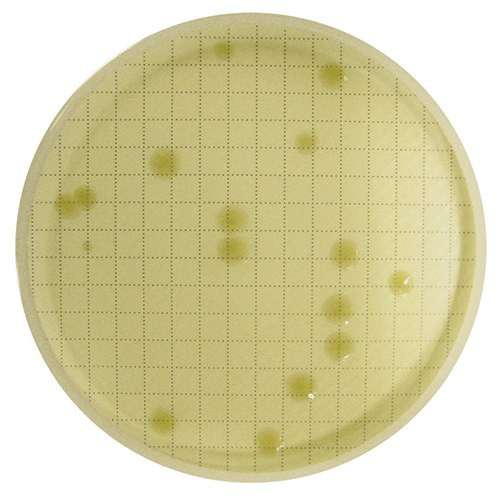
Reincubated agar plate with visibly grown bacteria colonies

Fluorescence-based Rapid Microbial Detection Technology Using Milliflex® Quantum System
Fluorescent-based detection methods allow faster microbial quality control throughout the manufacturing process. The ability to obtain microbial test earlier enables to keep pace with increasing demand and allowing corrective actions in case of contamination.
Fluorescent Staining
Florescence-based detection of microorganisms is based on membrane filtration. After filtration and incubation, reagent is applied to the membrane, staining any retained viable and culturable microorganisms with a fluorescent marker. The reaction requires active microbial metabolism for enzymatic cleavage of a non-fluorescent substrate. Once cleaved inside the cell, the substrate liberates free fluorochrome into the microorganism cytoplasm (Figure 1). As fluorochrome accumulates inside the cells, the signal is naturally amplified. The cells are then exposed to the excitation wavelength of the fluorescent dye so that they can be visually counted.

Figure 1.Fluorescent staining.
Milliflex® Quantum Rapid Detection System
The Milliflex® Quantum system is designed for fast, fluorescence-based quantitative detection of microorganisms over a broad range of filterable matrices. It detects microbial colonies long before they become visible to the eye and thus significantly reduces the time to result compared with traditional microbiological methods.
Milliflex® Quantum does not destroy the detected micro-colonies - it is therefore possible to identify any detected microorganisms by subsequently using your current identification methodology.

- Detection times for most microorganisms between 8 – 48 hours
- Easy-to-use and simple workflow, requiring minimal training
- Compatible with any ID technology
- Results comparable to compendial method, facilitating Milliflex® Quantum validation
- Economical, robust system
- Compact hardware
Validated by Industry Peers

Dr. Marcel Goverde
Managing Director, MGP Consulting, Switzerland
“Milliflex® Quantum was successfully validated as a rapid alternative method to the traditional bioburden testing”

Dr. Tim Sandle
Ph.D., Head of Microbiology, Risk Management, and Sterility Assurance at Bio Products Laboratory Limited.
Read the study by Tim Sandle
Watch the on-demand webinar
Applications
- Raw material (media, buffers, pharmaceutical ingredients and water)
- In-process samples (bioburden prior to sterilization, CIP/SIP samples, cell culture/fermentation samples, media for fermentation, buffers for manufacturing, and intermediate process samples)
- Final product
- Environmental samples
Rapid Bioburden Testing Workflow
The Milliflex® Quantum system is based on two proven technologies: membrane filtration and fluorescent staining.
1. Sample Preparation
The Milliflex® Quantum method utilizes proven Milliflex Oasis® membrane filtration devices for sample preparation, which ensures consistent, reliable results. Filter the desired sample volume Milliflex Oasis® presterilized, disposable Milliflex® filter units. Place membrane filter base onto a prefilled agar cassette and incubate.
Learn more about Milliflex Oasis® membrane filtration system.
2. Fluorescent staining
Transfer membrane to a pad pre-wetted with fluorescent reagent and incubate for 30 minutes.
3. Counting CFU’s
Count fluorescent colonies through the window of the Milliflex® Quantum reader or use the camera to view the colonies on your computer screen

Visualize plate after staining. View of the membrane in the reader.

CFUs are not visible outside of the reader.
After reincubation, CFUs are visible to the eye.
Example: Tested sample of in-process, non-sterile water using the Milliflex® Quantum system. After detection, membrane was reincubated for full growth and Identification.
4. Reincubation
Reincubate for identification of the microorganisms. Place membrane on a prefilled agar media cassette and reincubate. Collect and isolate the microorganisms and identify using any existing ID methodology.
Milliflex® Quantum Spot Counter Software
The Milliflex® Quantum camera combined with the Milliflex® Quantum Spot Counter software makes the sample reading more convenient and allows you to track records for optimized microbiology QC labs. Download the software here.
Service Offering
We provide technical support and a comprehensive service offering to help you save your QC resources and facilitate the implementation of your Milliflex® Quantum into your daily testing routine. Our highly experienced teams are there to assist you.
Materials
如要继续阅读,请登录或创建帐户。
暂无帐户?